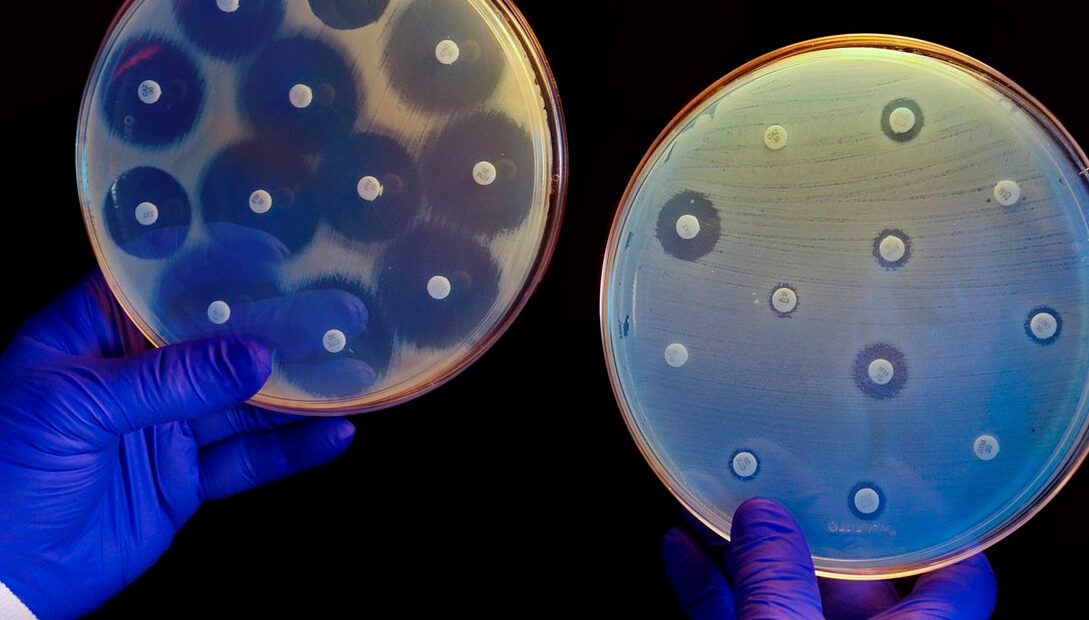

La resistencia bacteriana a los antibióticos podría convertirse en la principal causa de muerte mundial para el año 2050, advirtió Francisco Saynes Marín, presidente de la Sociedad Mexicana de Otorrinolaringología y Cirugía de Cabeza y Cuello. Este fenómeno, que amenaza con provocar hasta 10 millones de muertes anuales, requiere medidas urgentes para ser controlado.
Factores detrás de la resistencia bacteriana
La resistencia bacteriana ocurre cuando las bacterias desarrollan inmunidad frente a los antibióticos debido a prácticas como:
- Uso inadecuado de antibióticos: Tratamientos innecesarios o mal administrados.
- Automedicación: Fenómeno común en países como México, donde los pacientes adquieren antibióticos sin prescripción.
- Contaminación ambiental: Residuos industriales de empresas farmacéuticas en fuentes de agua que terminan en cultivos y ganado, llevando antibióticos al consumo humano.
La resistencia ha crecido un 10% en los últimos tres años y las muertes relacionadas con este problema han aumentado un 171%, según cifras destacadas por Saynes Marín durante la Semana Mundial de la Concientización sobre la Resistencia a los Antimicrobianos, convocada por la OMS.
Impacto en la salud pública
El uso indiscriminado de antibióticos no solo compromete su efectividad, sino que también provoca que las bacterias adquieran información genética para resistir futuros tratamientos. Esto genera infecciones más difíciles de tratar y aumenta el riesgo de complicaciones graves e incluso la muerte.
Soluciones necesarias
Saynes Marín subrayó la importancia de educar tanto al público como al personal médico sobre el uso adecuado de antibióticos. Además, señaló acciones esenciales:
- Diseñar planes gubernamentales para sanear las aguas de riego contaminadas.
- Mejorar la regulación de la industria agropecuaria para evitar el uso indiscriminado de antibióticos.
- Implementar campañas de concientización que promuevan la ética médica y la correcta administración de medicamentos.
Conciencia global en noviembre
La Semana Mundial de la Concientización sobre la Resistencia a los Antimicrobianos busca alertar sobre este problema y promover acciones para revertirlo, antes de que se convierta en una crisis sanitaria sin precedentes.